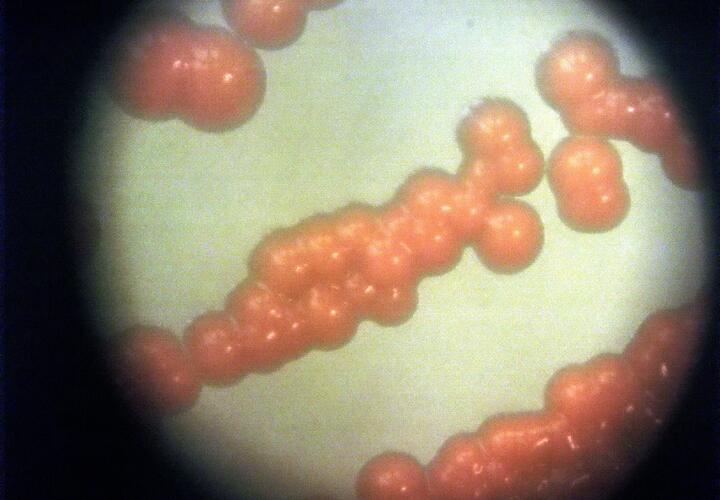
Эксперты не исключают масштабной пандемии в 2026 году

Учёные всерьез стали говорить о риске новой масштабной пандемии, которая может начаться уже в 2026 году. Причиной являются несколько вирусов, которые сейчас активно распространяются по миру и при этом всё хуже контролируются вакцинами.
В зоне риска сразу четыре инфекции:
- оспа обезьян;
- краснуха;
- птичий грипп;
- вирус Оропуш.
Специалисты отмечают, что уровень прививок снижается, а сами вирусы становятся более устойчивыми и быстрее меняются.
Оспа обезьян больше не считается редкостью. Вспышки фиксируют в разных странах, в том числе в Европе. Болезнь распространяется активнее, чем раньше, и даёт новые штаммы.
Краснуха, которую долгое время считали почти побеждённой, тоже может вернуться. Всё из-за того, что люди стали реже прививаться комплексной вакциной от кори, паротита и краснухи.
Отдельное беспокойство вызывает птичий грипп. Он уже научился передаваться от птиц к млекопитающим. Это повышает риск заражения человека и делает вирус потенциально опасным для массового распространения.
Есть и менее известная угроза - вирус Оропуш. Его переносят кровососущие мошки. Болезнь уже встречается в странах Америки и всё чаще фиксируется у туристов. Эксперты говорят, что каждый из этих вирусов сам по себе опасен. Но главная угроза в том, что на их фоне может появиться новый, неизвестный штамм, так называемый вирус «X». Именно он и может стать причиной масштабной пандемии.
Расслабляться рано: врачи рассказали, какой грипп придет после гонконгского, сообщала ранее «Живая Кубань».
Самые важные новости теперь в нашем Telegram-канале. Подписывайтесь, чтобы не пропустить: https://t.me/live_kuban.